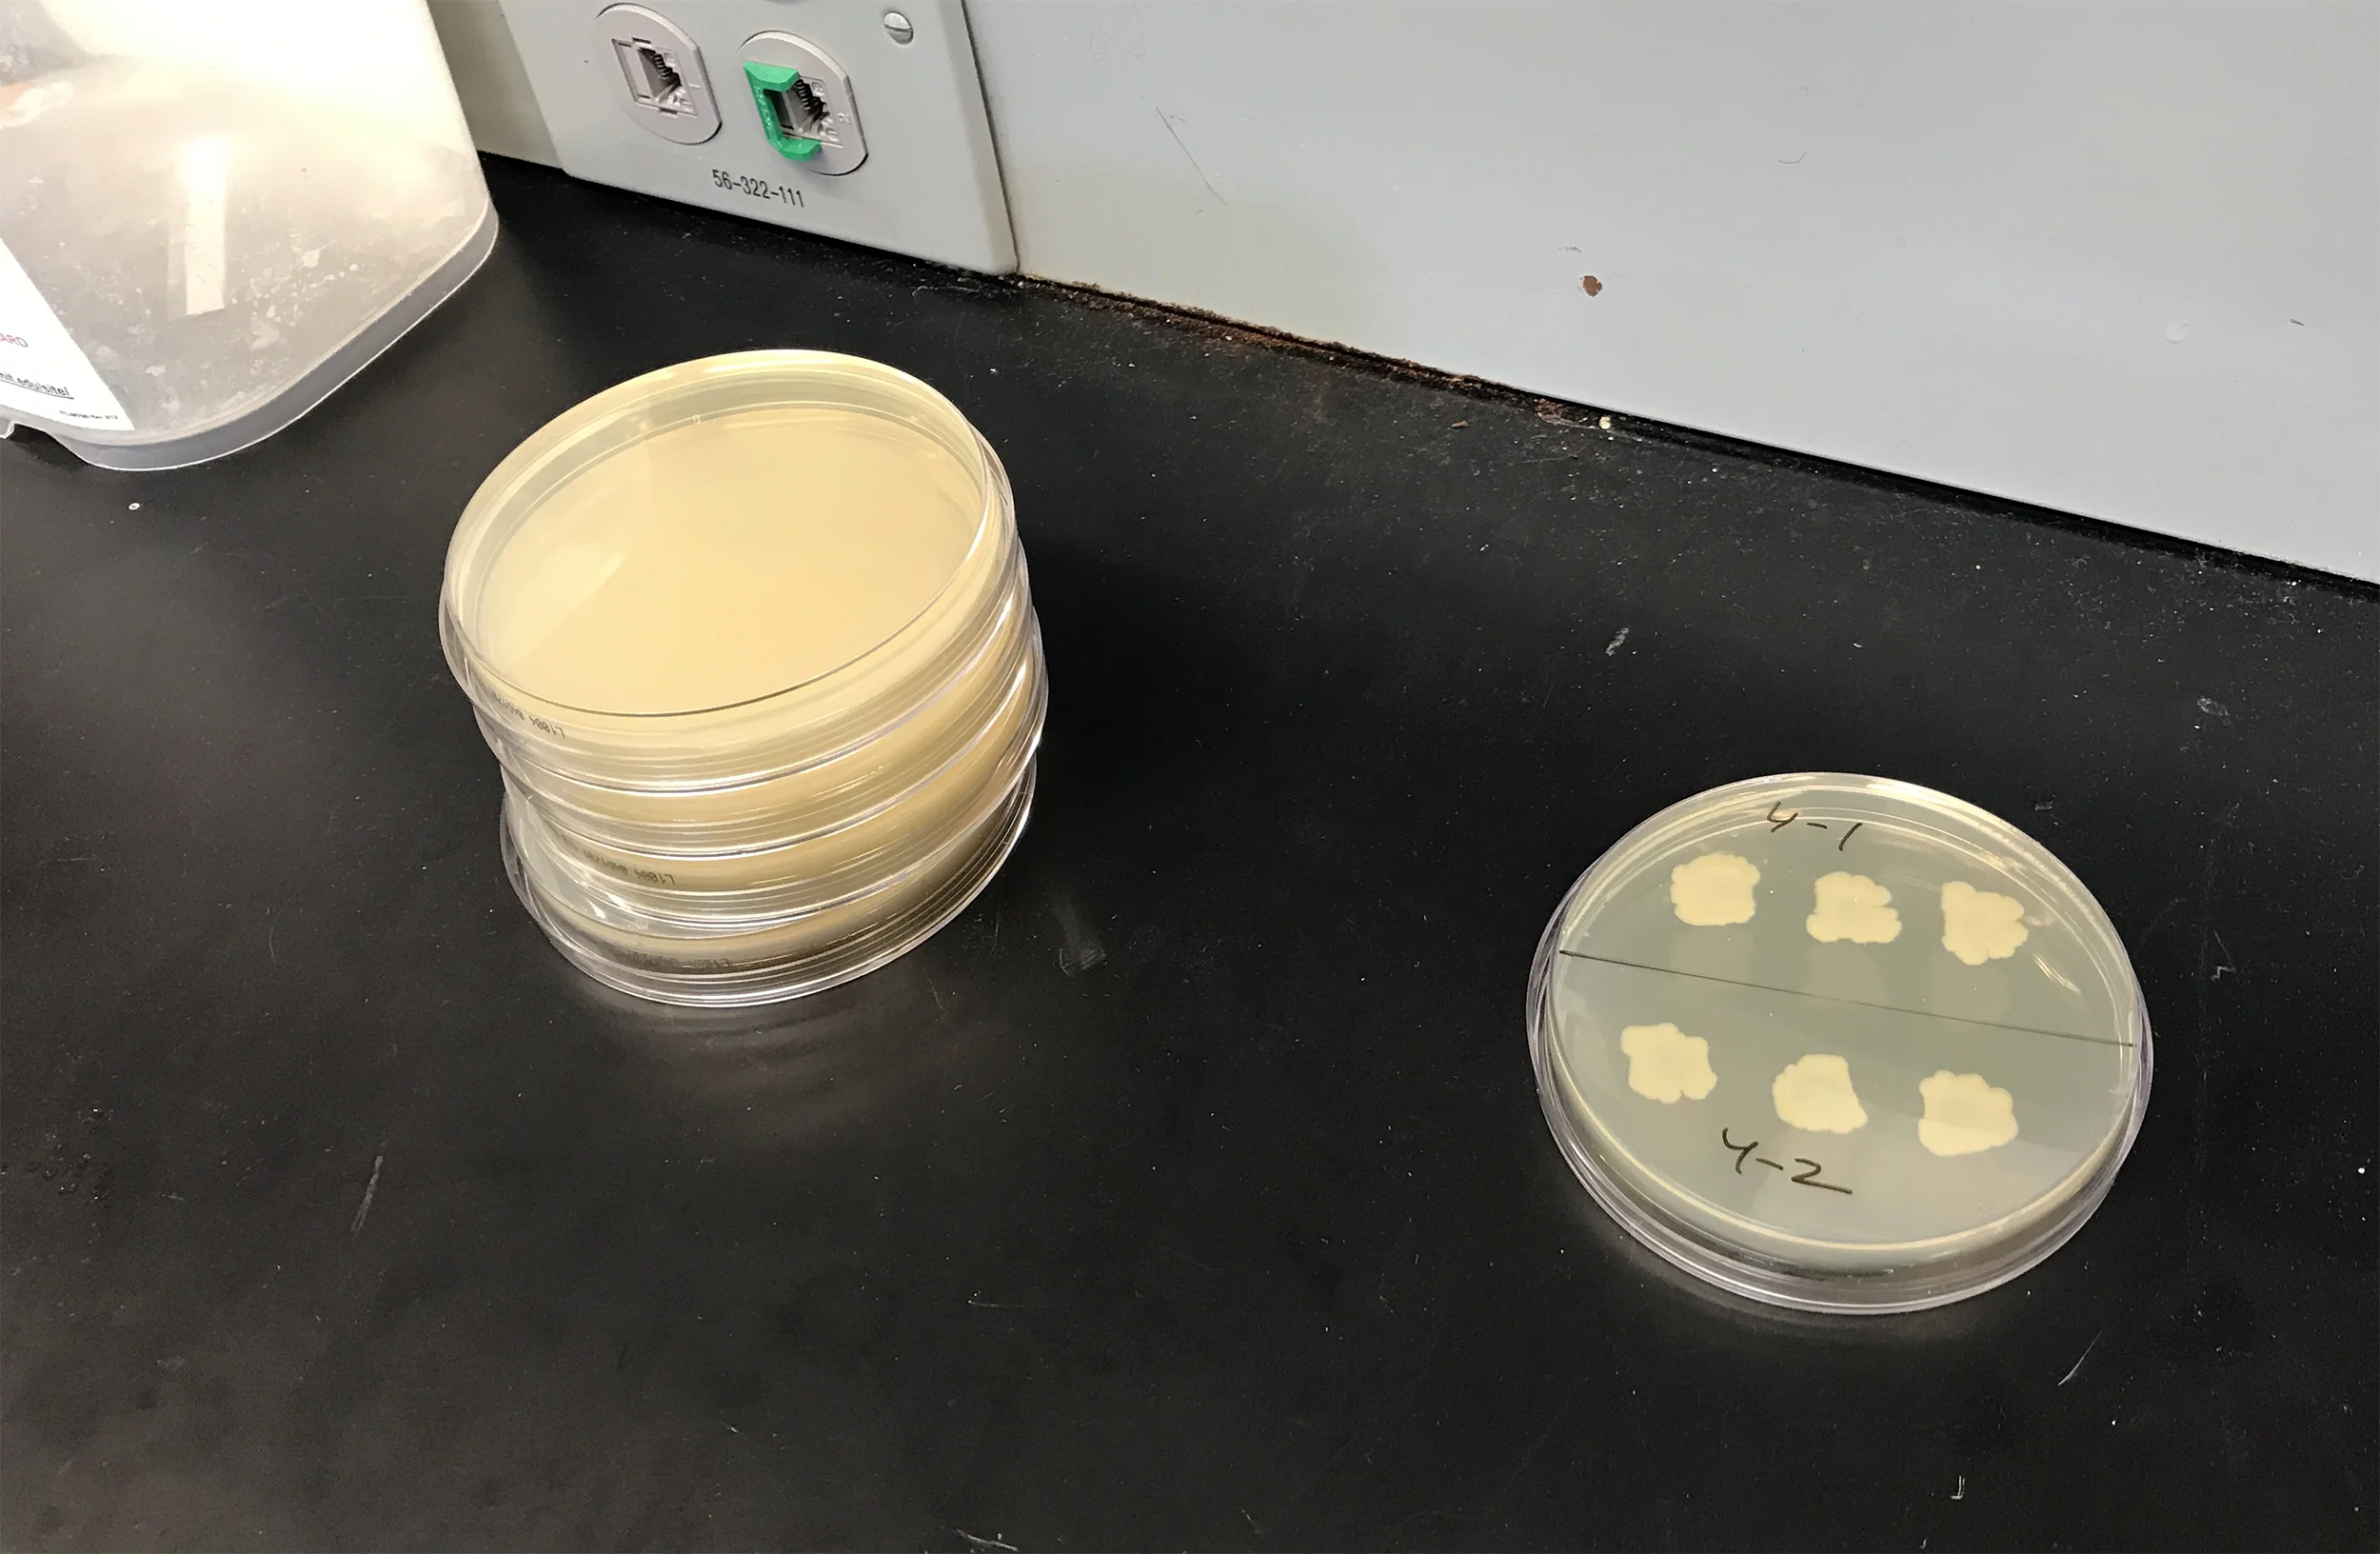

BioBuilder

BioBuilder
$0.00
We are excited to be taking part in BioBuilder's Professional Development Workshop next week at MIT! You can follow the amazing work being done at BioBuilder here. Please check back soon for updates on what we develop.
